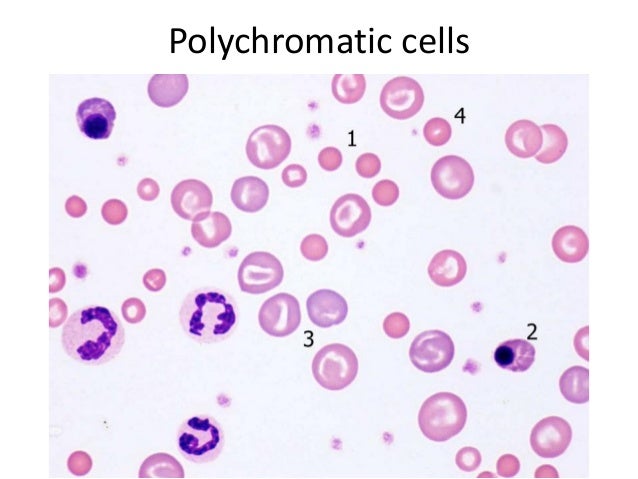
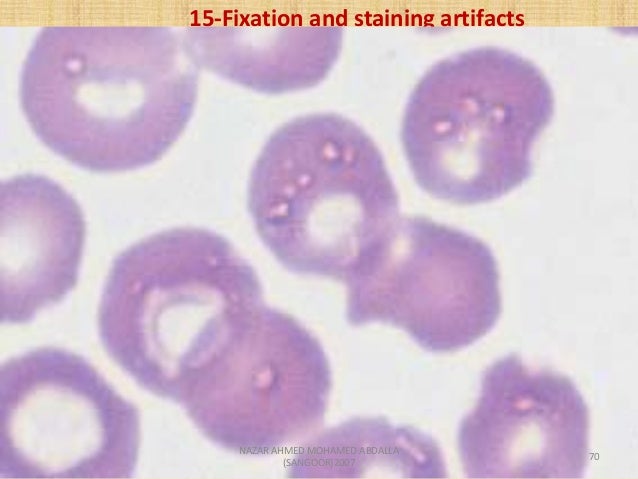
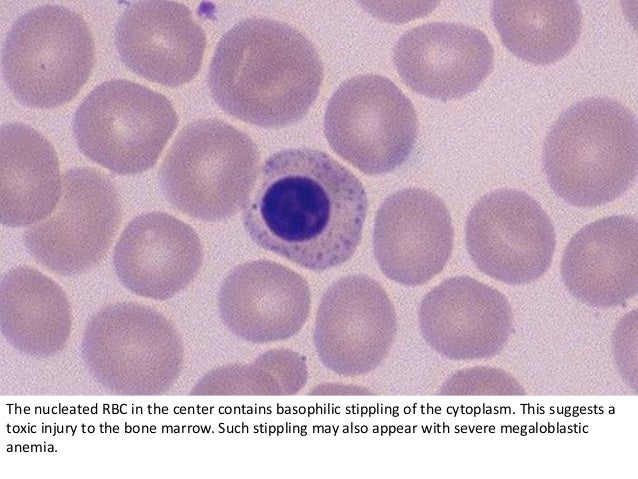

Polychromatic Rbc Images

Polychromasia What It Is Causes Symptoms Treatment

What S Wrong With That Red Blood Cell Slideshow Quiz By Sbme

Hematopoiesis

Pathology Thread

Polychromasia Wikipedia

Jaypeedigital Ebook Reader


Cureus A Rare Case Of Hemoglobin E Beta Thalassemia And Systemic Lupus Erythematosus
Rbc Disorders 1

Frontiers The Shape Shifting Story Of Reticulocyte Maturation Physiology

Red Blood Cell Indices Colour And Size A Laboratory Guide To Clinical Hematology
Rbc Normal Drone Fest

Morphological Abnormalities Of Red Blood Cells The Art Of Medicine

Complete Blood Cell Count And Peripheral Blood Film Its Significant In Laboratory Medicine A Review Study Science Publishing Group
Polychromatophilic Red Cells 1

Red Blood Cell Indices Colour And Size A Laboratory Guide To Clinical Hematology

Erythrocyte Production And Destruction Oncohema Key

Red Blood Cell Indices Colour And Size A Laboratory Guide To Clinical Hematology

Morphological Abnormalities Of Red Blood Cells The Art Of Medicine

Fhea Ch 4 Hematology Flashcards Chegg Com

Figure 1 From Immune Mediated Hemolytic Anemia Imha In Cats Part 1 A Review Immuungemedieerde Hemolytische Anemie Bij Katten Deel 1 Een Literatuuroverzicht Semantic Scholar

Sickle Cells Drepanocytes A Laboratory Guide To Clinical Hematology

Where Are Red Blood Cells Produced What Is The Average Life Span Of A Rbc Socratic

Rbc Pics Flashcards Quizlet

Red Blood Cells Maturation Medical Laboratories

Haematopoiesis Lab Learning Objectives Identify The Hematopoietic Precursor Cells Of A Typical Bone Marrow Smear Differentiate Between Precursors In Granulopoiesis And Erythropoiesis Lab Content Introduction The Bone Marrow Smear Can Be Used To

Polychromatic Red Cells Www Haematologyetc Co Uk

Dimorphic Population A Laboratory Guide To Clinical Hematology

Erythrocytes

Polychromatic Erythroblast Medical Laboratory Scientist Hematology Medical Laboratory Science

Complete Blood Count Vca Animal Hospital

Documents Ctcd Edu Lhansen Images Rbc

Erythropoiesis Wikivet English

Haematology Atlas Of Erythrocyte And Thrombocyte Abnormalities Free Medical Atlas

Avian Hematology Slides Ppt Video Online Download

Hemolytic Anemia Evaluation And Differential Diagnosis American Family Physician

Erythrocyte Morphology And Its Disorders Intechopen

Ppt Red Blood Cells Anemias Powerpoint Presentation Free Download Id

Clinical Pathology Polychromatophilic Red Blood Cell

Haematology In A Nutshell Polychromasia

Erythrocyte Production And Destruction Rodak S Hematology Clinical Principles And Applications 5th Ed

Images Of Anemia

Hemogram May Of 01 Red Blood Cells Showed Anisocytosis Download Scientific Diagram

Clinical Lab Hematology Flashcards Quizlet

Peripheral Blood Smear Shows Features Of Hemolysis Manifested As Download Scientific Diagram

Red Blood Cell Inclusions And Abnormalities Hematology

Rbc Disorders 1

Reticulocytes Flashcards Quizlet

Effects Of Therapeutic And Toxic Agents On Erythrocytes Of Different Species Of Animals Intechopen

Polychromatic Red Cells Www Haematologyetc Co Uk

Figure Reticulocytes Polychromatic Polychromatophilic Red Blood Statpearls Ncbi Bookshelf

Erythropoiesis

How Do Red Blood Cells Function Without A Nucleus Quora

Bone Marrow Cells Normochromatic Erythrocytes Nce In Yellow Orange Download Scientific Diagram

Erythrocytes

Nucleated Red Blood Cell Wikipedia

Polychromasia High Res Stock Images Shutterstock

Effects Of Therapeutic And Toxic Agents On Erythrocytes Of Different Species Of Animals Intechopen

Red Blood Cell Indices Colour And Size A Laboratory Guide To Clinical Hematology

Genetic Manipulation Of Cell Line Derived Reticulocytes Enables Dissection Of Host Malaria Invasion Requirements Nature Communications

Spherocytes A Laboratory Guide To Clinical Hematology
Polychromasia Wikipedia

Effects Of Therapeutic And Toxic Agents On Erythrocytes Of Different Species Of Animals Intechopen

Complete Blood Cell Count And Peripheral Blood Film Its Significant In Laboratory Medicine A Review Study Science Publishing Group

Morphological Abnormalities Of Red Blood Cells The Art Of Medicine

Erythropoiesis Wikivet English

Erythrocyte Morphology And Its Disorders Intechopen

Hematologyoutlines Atlas

Detail View Sysmex

Development Red Blood Cells Infographics Vector Stock Vector Royalty Free

Rbc Disorders 1

Nucleated Red Blood Cell Wikipedia

Hematologyoutlines Atlas

Erythropoiesis Wikipedia

Morphology Of Peripheral Blood Erythrocytes Wright Giemsa Download Scientific Diagram

Hematological Morphological And Morphometric Characteristics Of Blood Cells From Rhea Rhea Americana Struthioniformes Rheidae A Standard For Brazilian Birds

Complete Blood Cell Count And Peripheral Blood Film Its Significant In Laboratory Medicine A Review Study Science Publishing Group

30 Medical Laboratory Science Ideas Medical Laboratory Medical Laboratory Science Laboratory Science

Peripheral Blood Cells Of The Leopard Grouper Mycteroperca Rosacea At Download Scientific Diagram

Erythrocyte Production And Destruction Rodak S Hematology Clinical Principles And Applications 5th Ed

Erythrocyte Production And Destruction Rodak S Hematology Clinical Principles And Applications 5th Ed
Haematopoiesis Wikipedia
Morphological Abnormality Of Red Blood Cell

1 Developemntal Characteristics Of Erythrocytes Download Scientific Diagram

Morphological Abnormalities Of Red Blood Cells The Art Of Medicine

Haematology In A Nutshell Polychromasia

Hematology Flashcards Quizlet

Hematology Flashcards Quizlet

Red Blood Cell Inclusions And Abnormalities Hematology

Red Blood Cell Production Erythropoiesis Rbc Series Cells Morphology Master Chart Images Youtube
Rbc Disorders 1

Abnormalities In Red Cell Md Abnormalities In Red Cell Shape Color Any Studocu

Morphological Abnormalities Of Red Blood Cells The Art Of Medicine

Blood Cell Identification Pictures Flashcards Quizlet

Red Blood Cell Inclusions And Abnormalities Hematology

Red Blood Cell Inclusions And Abnormalities Hematology

Red Blood Cell Inclusions And Abnormalities Hematology

Red Blood Cell Inclusions And Abnormalities Hematology

Mlt Hematology Study Guide Part One Flashcards Quizlet

Erythrocyte Production And Destruction Rodak S Hematology Clinical Principles And Applications 5th Ed